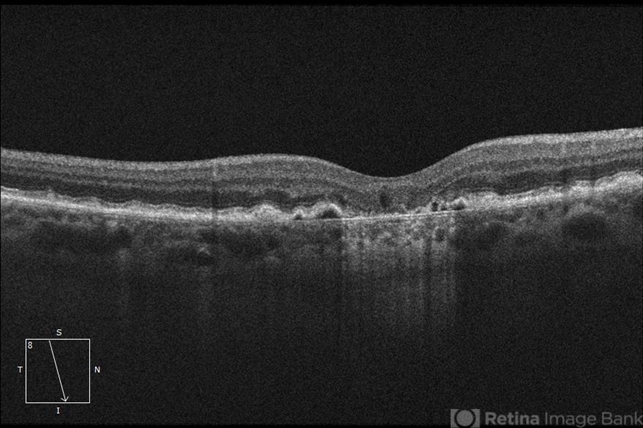
file

-
 By Darin R. Goldman, MD
By Darin R. Goldman, MD
Retina Group of Florida - Uploaded on Dec 12, 2019.
- Last modified by Caroline Bozell on Dec 12, 2019.
- Rating
- Appears in
- Miscellaneous
- Condition/keywords
- geographic atrophy, dry age-related macular degeneration (dry AMD), optical coherence tomography (OCT)
- Description
- This OCT B-scan shows geographic atrophy (GA) in dry age-related macular degeneration. There is focal atrophy of the RPE and outer retinal layers underneath the fovea, which is typical of GA. The loss of RPE in the affected area, relative to the surrounding macula, results in reverse shadowing within the underlying choroid. This effect is due to more penetration of the optical signal from the OCT illumination source owing to a relative absence of light being reflected as it normally would be from intact RPE. The result is a distinct border on each side of the affected area, where the underlying choroidal signal is more intense than the immediately adjacent areas. Additionally, adjacent to the area of GA are typical drusen, which are nodule-like diffusely hyperreflective accumulations within and under the RPE/Bruch complex, and pigment epithelial detachments (PEDs), which are nodule-like elevations of the RPE with underlying hyporeflective spaces.

Initializing download.
Initializing download.





---thumb.jpg/image-square;max$79,0.ImageHandler)




